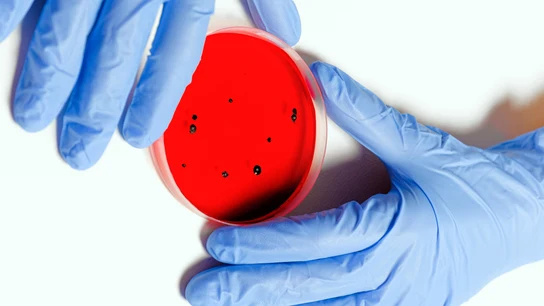

Tras la sentencia contra Cosentino

Tras la sentencia contra Cosentino

Lo explica Ricardo Moure

Antes de cocinarlo

No puede llevar pantalones ni bermudas

Una dura experiencia

Tras pasar unos días en el hospital

Enfermedad crónica

¿Se puede evitar?

Relegará algunos compromisos artísticos

Sus médicos no creyeron que fuera a sobrevivir

Aviso de la Fundación Pasqual Maragall

Problema en el sistema digestivo

Mejor, gracias al café

España es el segundo país con más casos

Alerta por el brote de ‘Monkeypox’
Enfermedades

Momento personal clave

En Asia